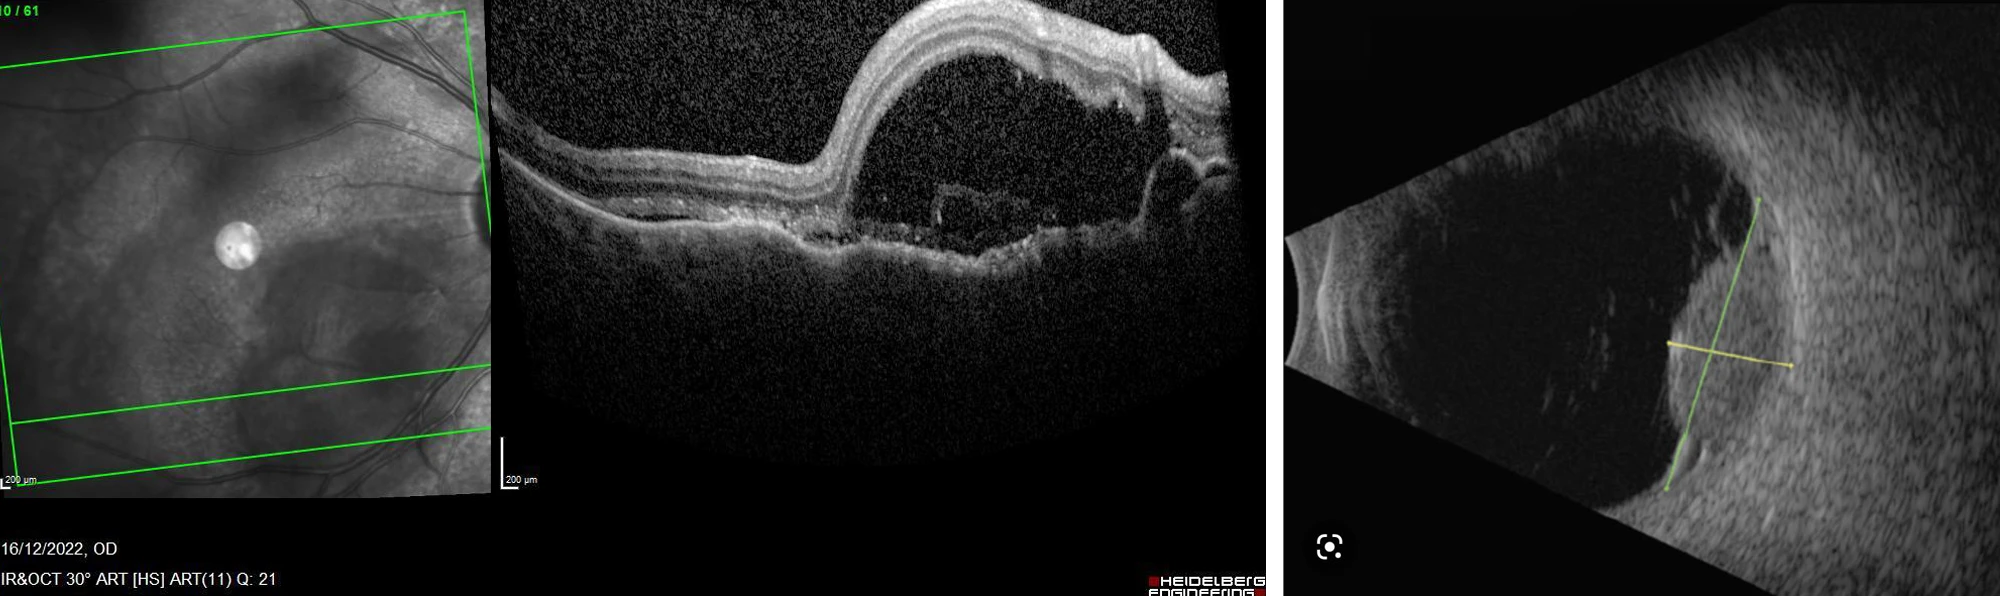
Image

May 2024

Author: Dr Brighu Swamy
A 64-year-old woman presents with slightly reduced vision in the right eye.
She described “feeling sick” for the last 4 weeks. No significant ocular or medical history was reported.
VA 6/18 OD, 6/6 OS

What is the most likely diagnosis?
A - Vogt-Koyanagi-Harada (VKH)
Oops! Try again
B - Central Serous Retinopathy (CSR)
Oops! Try again
C - Choroidal Neovascular Membrane (CNVM) secondary to Age-Related Macular Degeneration (AMRD)
Oops! Try again
D - Choroidal Metastases
CORRECT!
Answer D
- Mean diameter 9.5mm with thickness of 3.2mm
- Most commonly yellow in colour
- Primary site detected before uveal tumour in 2/3 cases
- Uvea most common site of ocular metastases due to large blood supply
- Choroid (88%), Iris (9%), ciliary body (2%)
- Breast most common site for primary in females
- Lung most common site for primary in males
- Kidney and GI malignancy next (4% each)
- Unknown in approximately 1 in 6















